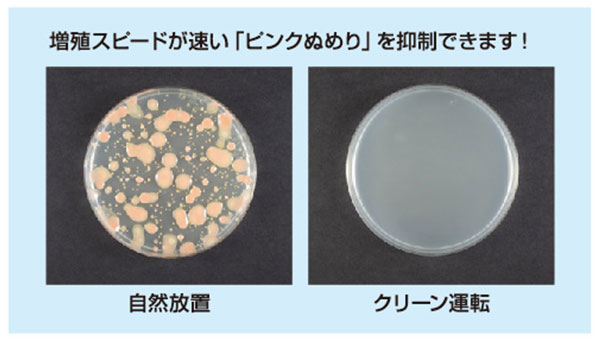

お風呂の
1dayリフォーム
お風呂の時間をより快適にしてくれるおすすめのリフォームをご紹介。
断熱性を高めてより過ごしやすく、清掃性を高めて日々の負担を軽減などなど、
今のお風呂をより快適な空間にしたい方におすすめです。
YKKAP
かんたんマドリモ
断熱窓
浴室仕様
お風呂と一緒に浴室マドもリフォームしませんか?
システムバスと同時に窓をかえて、空間の印象も一新!

商品価格
交換工事費
特徴
-
アルミ樹脂複合サッシの特徴 居室仕様/浴室仕様
アルミ樹脂複合フレーム+Low-E複層ガラスが優れた断熱効果を発揮。

-
Point1 工程に無理なく組み込めます

-
Point2 窓のサイズも変えられます
引違い窓と断熱パネル入FIX窓の連窓・段窓を使うことで、新設窓を最適な配置にすることができます。
※アルミ樹脂複合窓のみ対応可能です。
-
Point3 窓だけの交換も可能です
窓が原因の冷え込みなどを効果的に軽減します。